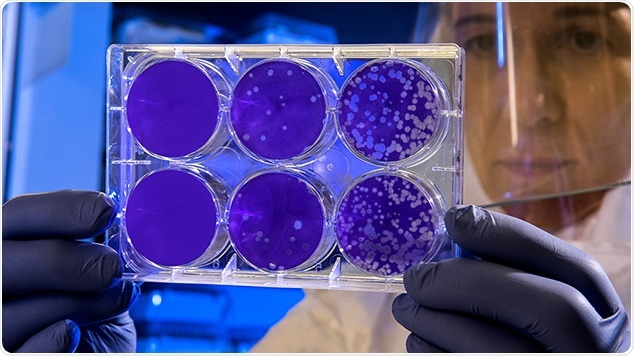

Point-of-care (POC) testing with screen-printed electrodes allows rapid testing of populations for viral outbreaks – at affordable costs, without the need for trained specialists and/or complicated equipment.
Image credit: Metrohm Middle East
A free white paper from Metrohm puts a focus on the viability of electrochemical testing citing a number of recent studies on the possibility of POC testing for viruses of various kinds. The white paper is of particular value for research groups working on solutions for rapid POC testing in the face of the current Corona pandemic.
The white paper discusses the possibility of rapid, POC testing for viruses of various kinds using cost effective and easy-to-use screen-printed electrodes (SPEs). Compared with other methods such as virus isolation cultures, enzyme-linked immunosorbent assay (ELISA), and other molecular methods (PCR, RT-PCR), electrochemical methods with SPEs promise straightforward, affordable testing at the point of care.
Metrohm DropSens is the world's leading brand for the manufacturing of screen-printed electrodes. The company is certified according to ISO 13485 for the «Manufacturing of sensors for medical devices» and offers the biggest catalogue in the market regarding materials and designs. Due to their longstanding expertise and large scale manufacturing capabilities, Metrohm DropSens has been a trusted supplier and partner to the pharmaceutical and other industries.